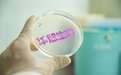
一个来自中国的全球化公司的成长故事——华熙生物亮相 2025 年第五届中国国际消费品博览会

2025年第五届中国国际消费品博览会,作为中国推动全球消费升级的“国家名片”,正以“共享开放机遇,共创美好生活”为主题,搭建全球品牌与前沿科技的超级展台。
在这场盛会上,华熙生物在5号国际馆构建了一座连接实验室与消费终端的科技桥梁——展台主视觉展示了糖生物学发展历程与华熙生物发展交织历程,象征中国生物科技企业从产业突围到定义全球标准的蜕变。
四次产业革命:从实验室到全球货架
1934年,哥伦比亚大学教授卡尔·迈耶首次发现透明质酸时,或许未曾预见这个糖链分子将掀起一场全球产业革命。20世纪70年代,西方企业凭借动物提取法(透明质酸的第一次产业革命)垄断透明质酸生产,但高昂成本(2000美元/克)将其禁锢于关节、眼科手术等狭窄领域。
直到21世纪初,华熙生物在中国首次实现了微生物发酵法规模化生产透明质酸,这一技术革新直接击穿了行业天花板,引发了透明质酸领域的第二次产业革命。2005 年,日本一家同行在参观华熙生物工厂后,迫于华熙生物因技术和工艺进步带来的成本及品质优势,决定退出食品级及化妆品级透明质酸原料市场;2007 年,华熙生物在透明质酸原料领域的市占率已跃居全球第一。这一颠覆性创新不仅让中国首次掌握了透明质酸产业的话语权,还推动了透明质酸的应用领域从医药向护肤、医美等领域广泛渗透,糖类物质产业应用初步形成。
尽管微生物发酵法的出现,大幅提升了透明质酸的生产效率,但透明质酸在自然界的分子量可以从几百道尔顿到数百万道尔顿不等,不同分子量的透明质酸在生物体内具有不同的功能和效果。如何生产出特定分子量的透明质酸,成为行业的新难题。
2011 年,华熙生物通过酶切法准确地控制透明质酸分子量,引发了第三次产业革命。这推动了基于不同分子量的透明质酸和其他糖胺聚糖的不同生物作用的探索,掀起了糖生物学的研究热潮,推动了聚糖生物机理的明确。华熙生物研究院发现小分子透明质酸可以通过神经调节免疫,促进组织修复,大分子透明质酸具有抑制炎症的能力。此外,在辅助生殖领域,在培养基中添加特殊分子量透明质酸明显改善了受精卵的存活率。这些深入研究揭示了透明质酸在通过调控细胞信号影响细胞行为方面的重要作用。在此期间,华熙生物已将透明质酸应用领域从眼科、骨科、医美、护肤,拓展至组织工程、肠道微生态、靶向药物递送等新兴领域。
自 2020 年起,华熙生物开始运用合成生物技术,通过细胞工厂生产透明质酸,开启了第四次产业革命。同时,华熙生物从生物学基础研究出发,聚焦于糖生物学和细胞生物学这两大方向,深入研究透明质酸以及其他糖类物质的作用机理,并发现糖类物质可以通过信号和修饰两种方式调控细胞和蛋白质的功能,从而管控炎症、细胞分化、甚至是癌症的发展。这为衰老干预和再生医学开辟了广阔的探索空间。
这些围绕小试、中试、工程放大的研究构成了产业转化的基础,正是基础研究、应用研究到产业转化的顺畅承接极大地降低了应用成本,提高了分子级别的控制精度,最终让多糖生物产业爆发出糖生物学开创者Karl Meyer完全无法想象的巨大空间。
当 2012 年美国国家研究委员会发布国家级战略指导型文件《转化酶科学:未来的风向标》,将糖生物学作为未来生命科学、医药和能源的重要发展方向时,华熙生物的生产线已同步将理论转化为消费级产品。这种 “实验室发现 → 中国转化 → 全球应用” 的闭环模式,在收购法国 Revitacare 后达到了新的高度。
四大业务板块的全球化布局
Revitacare 凭借其全球领先的中胚层美塑疗法技术和系列高科技美容护肤产品,成功吸引了世界的瞩目。其中,核心技术 —— 中胚层美塑疗法,通过精准定位皮肤中层,将高浓度的活性成分直接输送至肌肤深处,实现快速且显著的美容效果。这家拥有纯正法国血统、产品远销全球 60 多个国家和地区的公司,如今已成为全球生物科技巨头华熙生物的全资子公司。
在本次消博会上,华熙生物携旗下生物活性物原料、医疗终端、功能性护肤品及功能性食品四大业务板块,以及润百颜、夸迪、米蓓尔、肌活、润致等国内外知名消费品牌亮相。同时,华熙生物还带来了皮肤定制化专区——将 3000 平方米的 GMP 药械级车间浓缩成一台双开门冰箱大小的个性化定制门店工作站。
在这里,消费者可以通过手机小程序进行智能 AI 肤质分析,华熙生物深入探究皮肤问题的本质成因,从细胞级层面出发,分析并定位肌肤问题的根源,从而提供定制化解决方案。
同时,华熙生物成功将前沿的“微流控”工艺应用于“一人量”产品的标准化生产中,这一技术原本多见于高端药企研究领域,其成功应用进一步提升了产品的品质与安全性。尤为突出的是,华熙生物能够实现量体裁衣式的定制服务,精准匹配不同个人的差异化需求。其精准配方平台覆盖了超过108种定制方案,有效应对 15625 种不同的皮肤状态,每一方案均经过科学验证与国家备案,确保产品的安全与功效。
中西方科研产业化互补
中国在科技成果转化方面拥有一个非常明显的生态优势:一旦基础研究取得突破,需要围绕产业链和供应链进行生产时,中国就能充分发挥其优势,因为围绕供应链的研发离不开工厂。
中国目前很多产业在全球的产能都占到 30% 以上,而且产能还在外溢。中国的工厂不止是制造中心,也是研发场景的重要部分,全球的研发转化链路也离不开中国的参与。以华熙生物为代表的中国企业,往往从产业优势出发,通过不断强化研发,形成了独特的全球科技成果转化生态优势。
而西方企业则更倾向于从研发突破入手,推动产业化进程。国际前沿的基础研究也需要跟中国的产业链供应链优势结合才能提高效率。中西方企业在科研与产业化上的互补优势,为双方的合作提供了广阔的空间。
华熙生物正是这一理念的践行者,华熙生物积极展开国际合作,将基础研究、应用研究和公司具优势的产业转化研究结合起来。通过与哈佛大学、加州理工大学等顶尖科研机构合作,深入探索细胞生物学和糖生物学领域,拓宽了华熙生物的研究边界,不断吸收全球创新资源,推动自身在生物科技领域的持续领先。
展望未来,华熙生物将继续秉持开放合作的态度,与国际顶尖科研机构及企业深化合作,共同推动生物科技领域的创新发展,为全球消费者带来更多高品质、创新性的生物科技产品,成为让世界尊敬、喜爱的民族企业。
“特别声明:以上作品内容(包括在内的视频、图片或音频)为凤凰网旗下自媒体平台“大风号”用户上传并发布,本平台仅提供信息存储空间服务。
Notice: The content above (including the videos, pictures and audios if any) is uploaded and posted by the user of Dafeng Hao, which is a social media platform and merely provides information storage space services.”